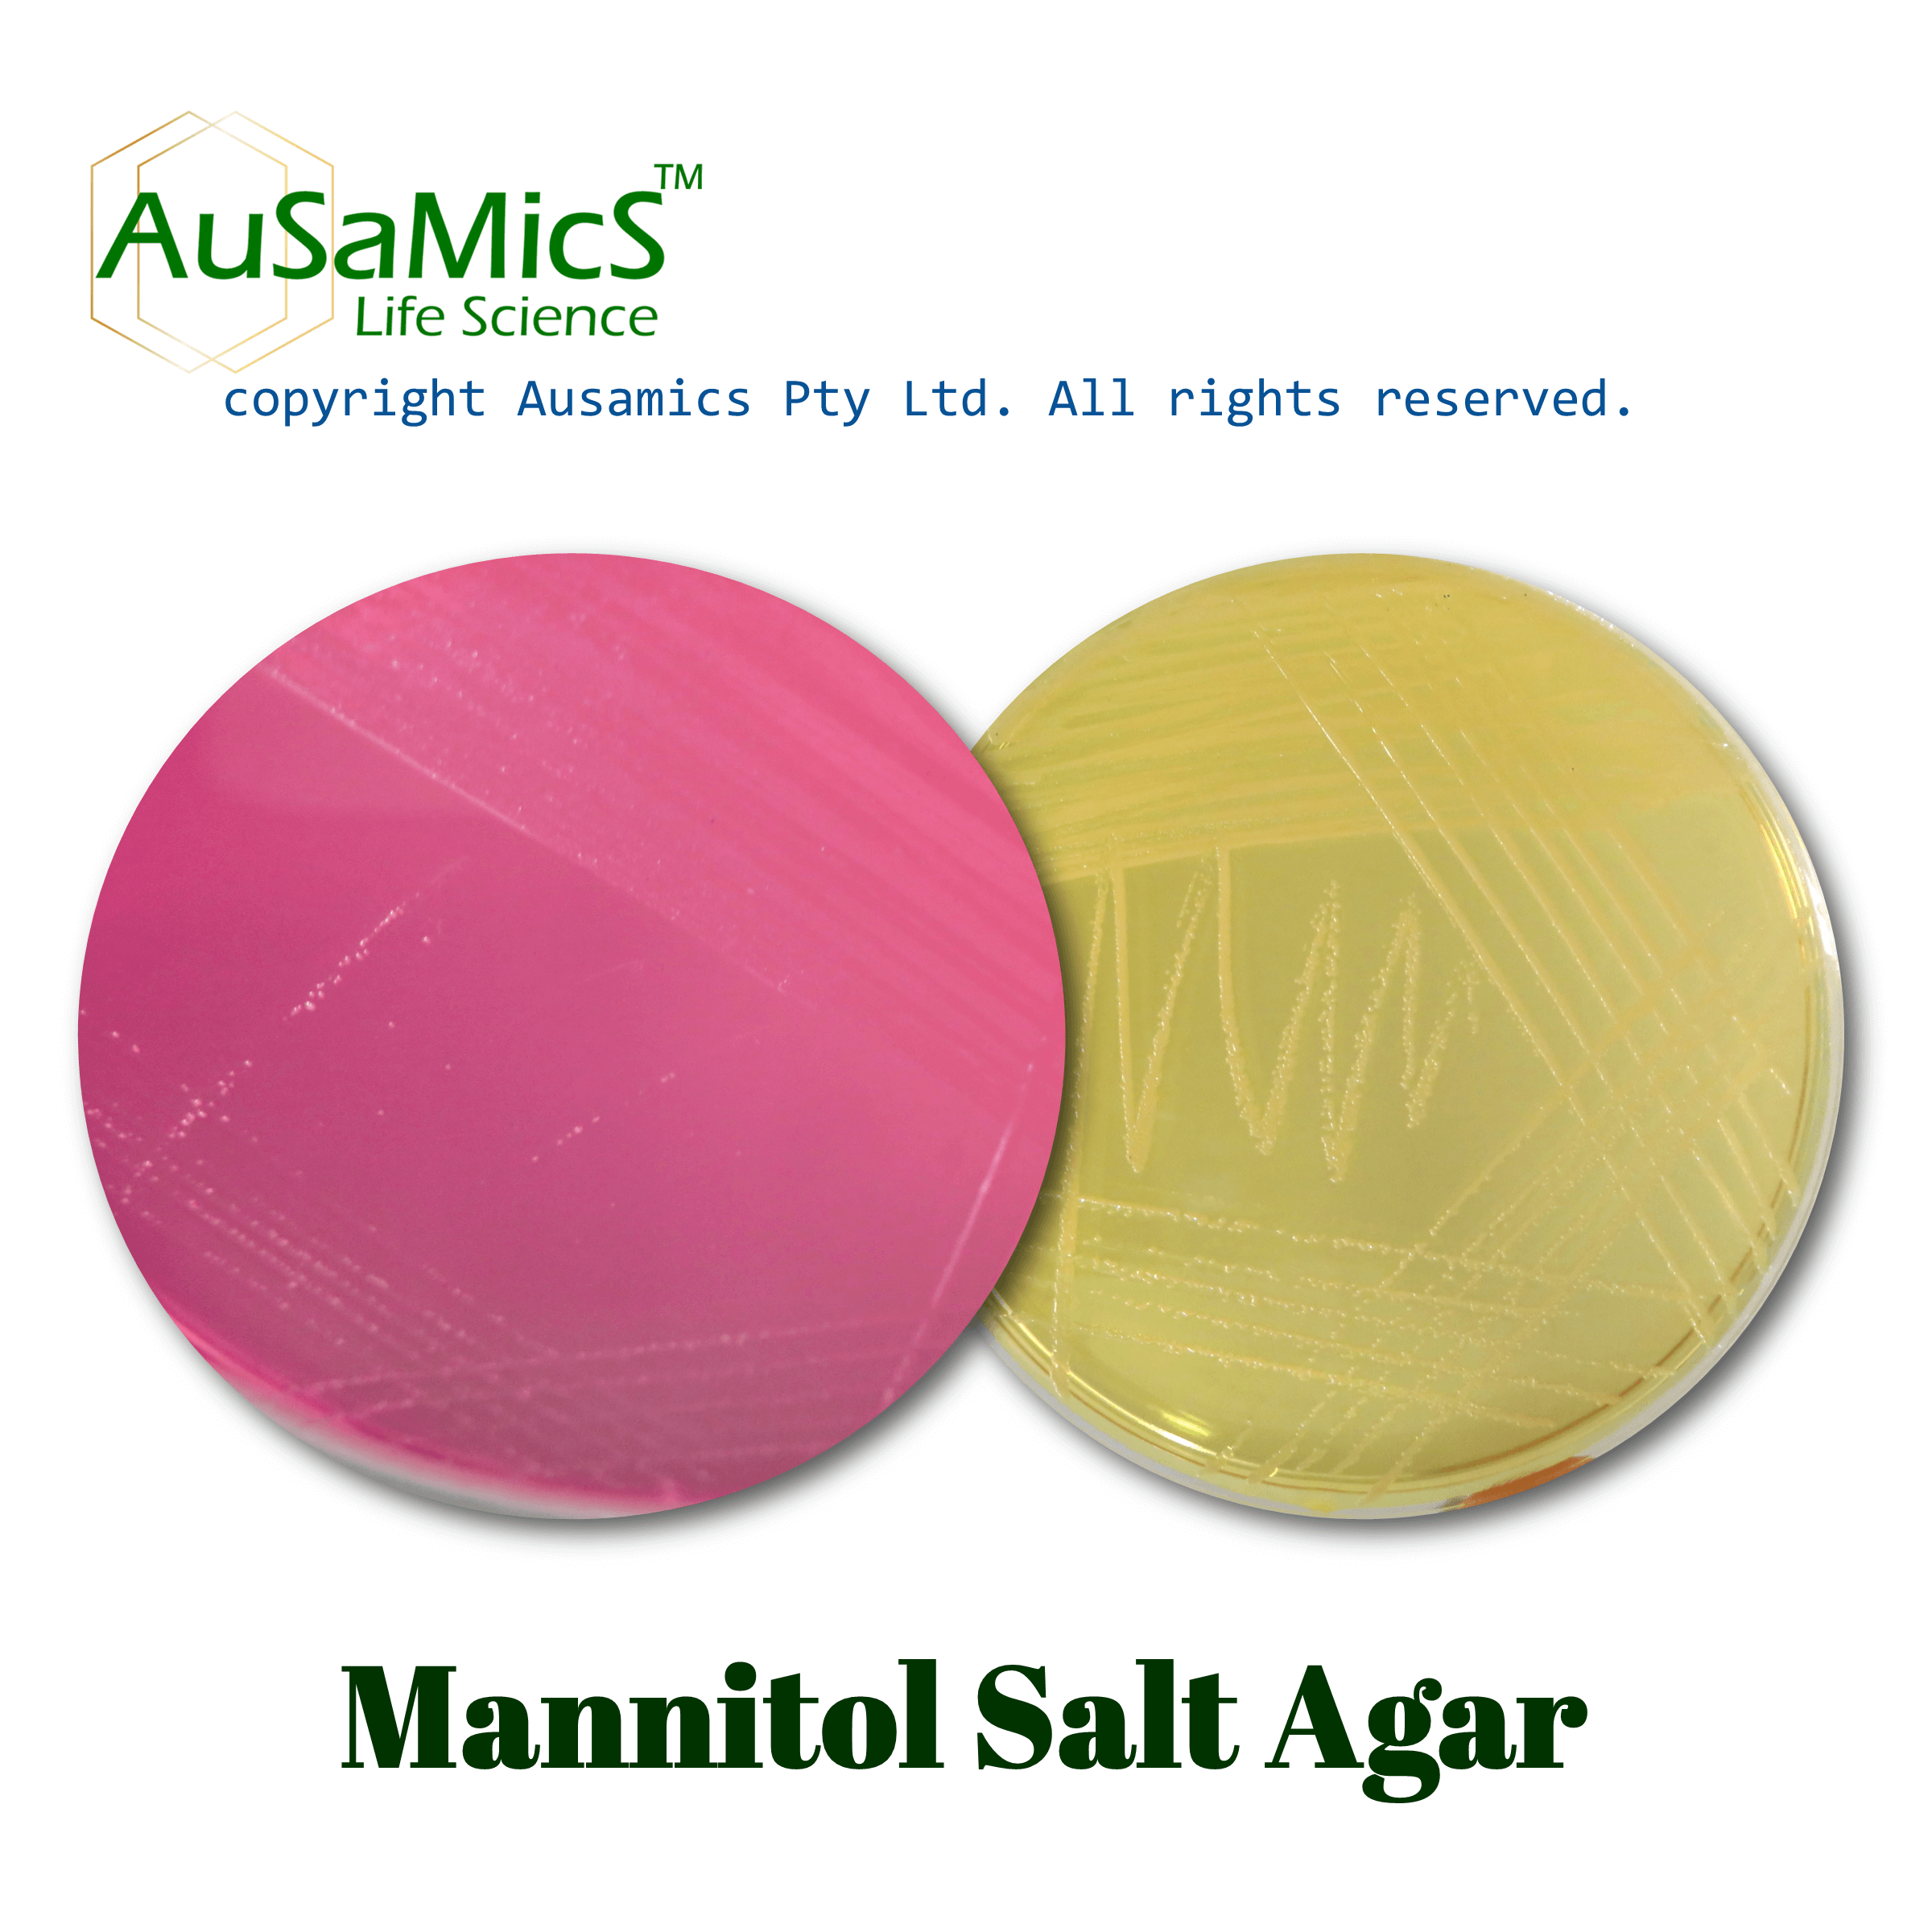
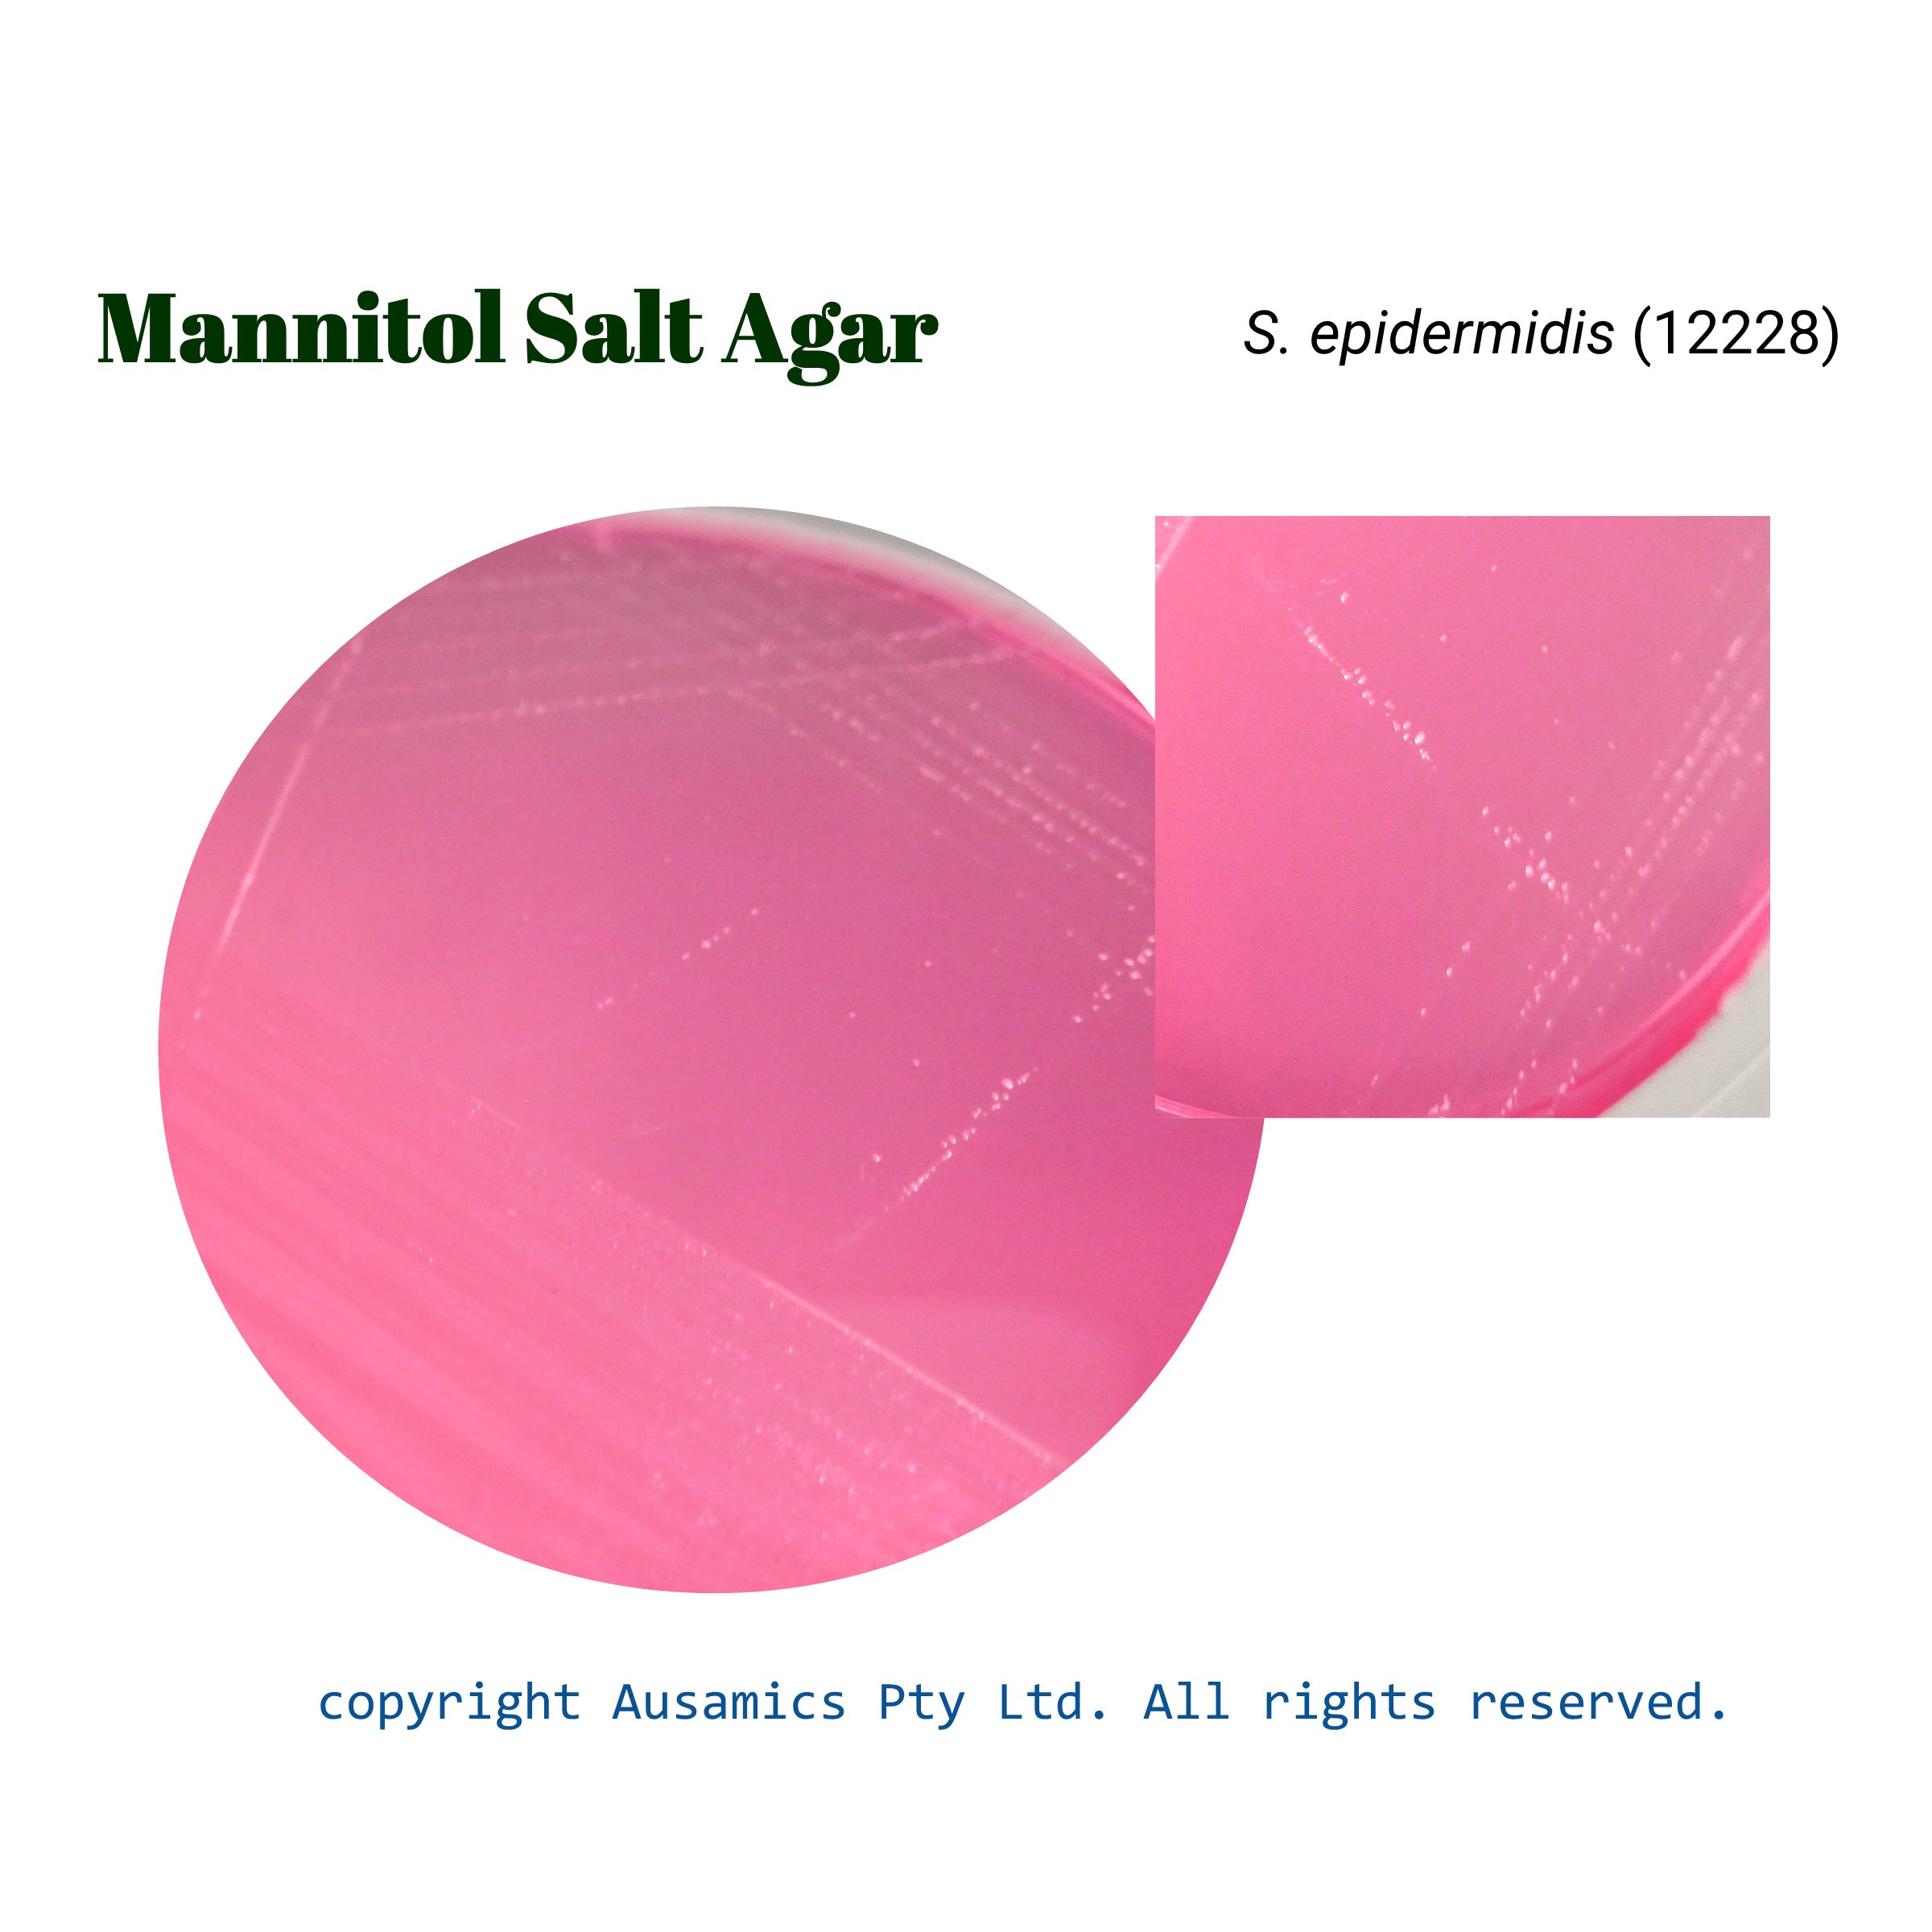

Mannitol Salt Agar
Used for selective isolation, cultivation, and enumeration of staphylococci.
- Description
- Composition
- Quality Control
- Microbial Test Results
Mannitol Salt Agar (MSA) is a selective and differential culture medium primarily used for the isolation and identification of Staphylococcus aureus. The high sodium chloride concentration (7.5%) renders the medium selective by inhibiting the growth of most microorganisms except for staphylococci, which are known for their salt tolerance.
MSA is also differential due to the inclusion of mannitol as a carbohydrate and phenol red as a pH indicator. Staphylococcus aureus is mannitol-fermenting, producing acid which causes lower the pH and result in a yellow coloration of the medium. Coagulase-negative staphylococci, unable to ferment mannitol, typically produce pink to red colonies.
Peptones provides essential nutrients for bacterial growth. Additionally, the medium can be supplemented with egg yolk emulsion to detect lipase activity, results in opaque zones around colonies due to lecithinase production. This enzymatic activity is often associated with pathogenic staphylococcal species.
Storage
Keep the container at 15-30 °C and prepared medium at 2-8 °C.
| Composition | gr/L |
| Pancreatic digest of Casein | 5 |
| Peptic digest of Animal Tissue | 5 |
| Beef Extract | 1 |
| Sodium Chloride | 75 |
| D-Mannitol | 10 |
| Phenol Red | 0.025 |
| Agar | 12 |
| Final pH at 25°C | 7.4 ± 0.2 |
| Dehydrated Appearance | Beige Fine, homogeneous, free of extraneous material and may contain many light to dark red flecks. |
| Prepared Appearance | Light to medium rose red, trace orange; clear to hazy. |
| Reaction of 10.8% Solution at 25°C | pH 7.4 ± 0.2 |
| incubate at 35 ± 2 °C for 42 to 48 hours. Incubate Staphylococcus aureus ATCC 6538 and E. coli ATCC 8739 at 30-35°C for 18-72 hours. | ||
| Organism (ATCC) | Recovery | Color of media around colony |
| Proteus mirabilis (12453) | Partial to complete inhibition | – |
| Escherichia coli (8739) | No Growth | – |
| Staphylococcus aureus (25923) | Good | Yellow |
| Staphylococcus epidermidis (12228) | Good | Red |
| Staphylococcus aureus (6538) | Good | Yellow |